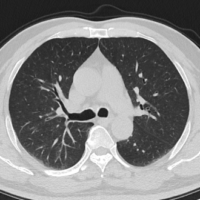
Apeikonish Thoraka

Αξονικής Τομογραφίας
Οι αξονικές τομογραφίες εκτελούνται με το σύγχρονο αξονικό τομογράφο 32 τομών SOMATOM go.Now του ομίλου SIEMENS.
Διαθέσιμο στα καταστήματα:

Στο Διαγνωστικό Κέντρο «Οι Άγιοι Ανάργυροι» εγκαταστάθηκε και λειτουργεί ο σύγχρονος Αξονικός Τομογράφος 32 ανακατασκευασμένων τομών Siemens SΟΜΑΤΟΜ go.Now.
O Αξονικός τομογράφος SOMATOM go.Now είναι εξοπλισμένος με τεχνολογίες αιχμής που συμβάλλουν στην άριστη ποιότητα διαγνωστικής απεικόνισης με τη λιγότερη δυνατή απαιτητή δόση για την ασθενή. Η παρουσία τεχνολογιών όπως ο ανιχνευτής Stellar και το ειδικό φίλτρο κασσίτερου (Tin Filter) στην έξοδο της λυχνίας, επιδρούν δραστικά στη μείωση του παραγόμενου θορύβου της εικόνας και σε συνδυασμό με τον προηγμένο επαναληπτικό αλγόριθμό ανακατασκευής SAFIRE αποδίδουν εξαιρετικής ποιότητας διαγνωστικής απεικόνιση με ταυτόχρονη δραστική μείωση της δόσης.
O Αξονικός τομογράφος SOMATOM go.Now είναι εφοδιασμένος με καινοτόμες τεχνολογίες για τη δημιουργία των πλέον φιλικών συνθηκών εξέτασης για τον ασθενή.
Συγκεκριμένα ο SOMATOM go.Now:
Είναι ο πρώτος αξονικός τομογράφος στον οποίο ο εξεταστής πραγματοποιεί το σχεδιασμό της εξέτασης μέσω tablet παραμένοντας συνέχεια δίπλα στον ασθενή και ελαχιστοποιώντας το χρόνο για τον οποίο ο εξεταζόμενος παραμένει μόνος του στο χώρο εξέτασης.


Διαθέτει ενσωματωμένη κάμερα για την επιτήρηση του ασθενούς καθ’ όλη τη διάρκεια της εξέτασης με ψηφιακή απεικόνιση αντίστροφης μέτρησης ολοκλήρωσης της εξέτασης για την άνεση του ασθενή και την παροχή βοήθειας για την τήρηση των χρόνων που θα κρατήσει την αναπνοή του ο ασθενής.
Έχει χαμηλά επίπεδα θορύβου λειτουργίας (μικρότερα από ένα αυτοκίνητο ή την ανθρώπινη ομιλία) δημιουργώντας πιο ευχάριστο περιβάλλον για τον ασθενή

Ενδεικτικά οι κυριότερες απεικονιστικές εφαρμογές του SOMATOM go.Now είναι:
- Απεικόνιση θώρακα με και χωρίς χρήση σκιαγραφικού
- Απεικόνιση κοιλίας
- Αξονική Οδοντιατρική Απεικόνιση (CT Dental)
- Αγγειογραφία
- Απεικόνιση εγκεφάλου
- Μυοσκελετικό
- Εικονική ενδοσκόπηση

- ΑΞΟΝΙΚΗ ΠΥΕΛΟΓΡΑΦΙΑ
- ΜΥΟΣΚΕΛΕΤΙΚΟΥ
- ΕΓΚΕΦΑΛΟΥ
- ΚΟΙΛΙΑΣ
- ΑΞΟΝΟΜΕΤΡΗΣΗ